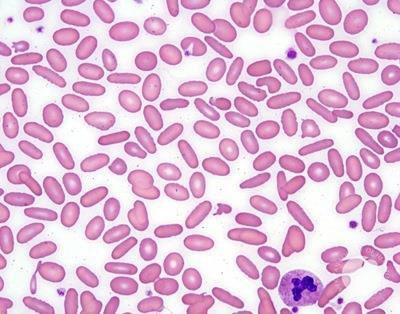
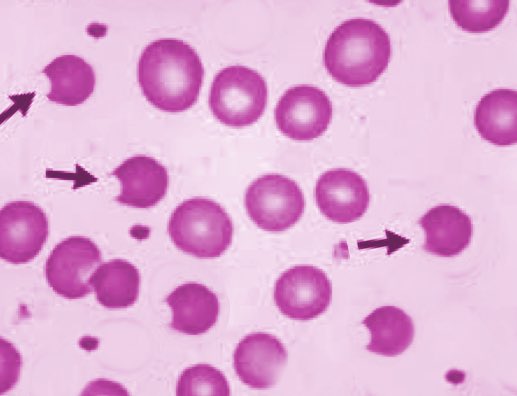

6- paroxysmal nocturnal hemoglobinuria(PNH):
طفره في جين خلايا النخاع PIGA gene يؤدي الى زياده حساسيه الخلايا الى ال complement binding , فالخلايا يكون فيها نقص CD55و CD59 الي وظيفتهم الاساسيه يعملو تثبيط لل complement
اهم الاختبارات :
١- ham’s and suger water test positive
طفره في جين خلايا النخاع PIGA gene يؤدي الى زياده حساسيه الخلايا الى ال complement binding , فالخلايا يكون فيها نقص CD55و CD59 الي وظيفتهم الاساسيه يعملو تثبيط لل complement
اهم الاختبارات :
١- ham’s and suger water test positive
جاري تحميل الاقتراحات...